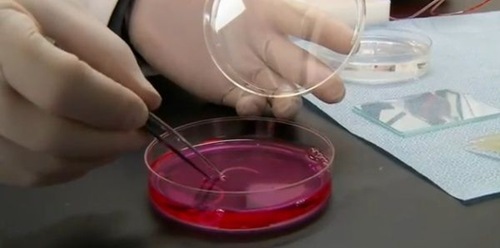
New Picture 82

Orphanages served as repositories for unwanted, illegitimate and unsupportable children in relatively recent yet still socially unenlightened times and places. Modern initiatives in family planning and social welfare along with the realization that institutionalizing children adversely affects their development have seen a steep reduction in the number of functional and operating orphanages. These 10 eerie abandoned orphanages represent a fading vestige of “the good old days” whose loss is in no way disappointing.
1. Greek Orphanage: Büyükada, Turkey
Images via: Archaeopop
The former Büyükada Greek Orphanage (Büyükada Rum Yetimhanesi) was designed in the Ottoman Beaux-Arts style by French-Turkish architect Alexandre Vallaury and opened in 1899. Its remote location on Büyükada, one of the Prince’s Islands just off Istanbul in the Sea of Marmara, probably contributed to its preservation even though it’s been abandoned since the 1960s.
Image via: Archaeopop
The orphanage closed in 1936 after running afoul of official regulations and was subsequently used as a government administration building. A lengthy court battle that finally ended in 2010 saw the title of the building returned to the Greek Orthodox patriarchate. It remains one of the world’s largest wooden buildings.
2. Abandoned Orphanage: Jena, former East Germany
Image via: ashes_and_sackcloth
This abandoned orphanage in the German city of Jena displays a jarring combination of hope and despair on its grimy facade: bright, colourful window frames epitomize the former while dull, lifeless masonry blighted by graffiti typify the latter. In its heyday, administered by authorities in the former German Democratic Republic, the place may have been almost cheery compared to the trials and tribulations of everyday life. Thanks to Flickr user ashes_and_sackcloth for capturing this unique emotional image.
3. Abandoned Orphanage Nursery: Pripyat, Ukraine
State-funded orphanages were common in most medium to large cities of the former Soviet bloc, though they are gradually giving way to family support programs and foster care. The process is slow, however - as of 2011 slightly over 100,000 children were residents of orphanages in Ukraine.
Image via: Imgur
Bad as that seems, at least children no longer reside in the orphanage at Pripyat, the city of 50,000 founded in 1970 and abandoned 16 years later in the wake of the Chernobyl nuclear disaster. Judging from the cramped conditions in the nursery above, life must have been difficult at best; depressing at worst.
4. St John’s Orphanage: Goulburn, New South Wales, Australia
Image via: Viewed At Once
St. John’s Orphanage (also known as the Goulburn Boys Orphanage) located in Goulburn, New South Wales, opened in 1912 and closed in 1976. At any one time, approximately 100 boys aged 5 to 16 called the Goulburn Boys Orphanage home. After the orphanage closed, the Christian Interdenominational Organisation conducted discipleship training courses in the building before it was finally abandoned in the late 1990s. The structure is reputed to be haunted and although entry into the interior is not allowed, nocturnal ghost tours are regularly conducted by a local company.
5. Abandoned Orphanage: near Paris, France
Images via: About-Photos-Weblog
Located in a small village south of Paris, this abandoned orphanage closed sometime around 1990 - seemingly in a rush, just before lunch time. It hasn’t been determined exactly how old the orphanage is: though some of the buildings show evidence of appreciable age, others exhibit obviously modern brickwork.
Images via: About-Photos-Weblog
It may have been an orphanage but the facility exudes some semblance of luxury - check out those skylights! Among the many buildings and outlying structures are stables, a tennis court, a small church, and a restaurant or canteen to name just a few.
6. Abandoned Orphanage: near Croix-des-Bouquet, Haiti
Images via: Moments of Clarity Are Not Answers
In May of 2011 Dave Korn travelled to Haiti, volunteered with Un Techo para mi País: “a non-profit organization that strives to improve the quality of life of impoverished families across Latin America through the construction of transitional housing and the implementation of social inclusion programs.” Almost a year and a half after the devastating 2010 Haiti Earthquake, the orphanage above was both abandoned and unconnected to power and water, forcing the volunteers to pitch tents in the building’s rooms. [More]
7. Holy Family Orphanage: Marquette, Michigan, USA
Images via: Chad R. Johnson, Sonofabunch and Shadow112886
Designed to accommodate 200 children, the Holy Family Orphanage in Marquette, Michigan opened in 1915 and closed in 1965 - it’s been abandoned since then; almost for as long as it was operating. The orphanage was built at the then-astronomical cost of $90,000 to $120,000 and featured bathrooms on every floor, an in-house laundry, and heating and plumbing facilities housed in an annex. The City of Marquette has been attempted to sell the building, valued at $400,000 but as yet there have been no takers…not even Stephen King.
Image via: Chad R. Johnson
Kudos to Flickr user Chad R. Johnson for the above and other photos of the Holy Family Orphanage’s overgrown majesty. Johnson’s “warts and all” images let the aged structure’s undeniable beauty shine unhindered through a thick patina of weathered neglect.
8. Royal Liverpool Seamen’s Orphanage: Liverpool, United Kingdom
Images via: 28 Days Later
The Royal Liverpool Seamen’s Orphanage in Newsham Park, Tuebrook, Liverpool was opened in 1870 to care for the orphaned children of families who had died at sea - judging from the immensity of this frightfully gothic structure, such a fate must have been quite common. The facility ceased to be an orphanage in 1949; becoming Newsham Park Hospital and then an old age home before being fully shuttered and boarded up in 1988. Consider it an architectural expression of the Great Circle of Life.
Image via: 28 Days Later
Several schemes have been put forth towards turning the character-rich derelict building and its 99,000 square feet of interior space into a housing estate but as yet, none have been approved and the structure continues to decay. The most lively activities being conducted there these days are organized by “ghost hunting” tours.
9. Abandoned Orphanage: Belgium
Images via: A.Ypeij/Panoramio
Time-tested construction of stone and wood soon deteriorates and decays while cheap plastic toys retain their newly-purchased lustre long after the last child has left the orphanage. Is this the fate of all Man’s earthly endeavours? It would seem so, if A.Ypeij‘s evocative image of an abandoned orphanage somewhere in Belgium is any indication.
10. Jesse Lee Home for Children: Seward, Alaska, USA
Images via: Daniel Hernandez, Alaska Dispatch & Friends Of The Jesse Lee Home
Opened in 1926 to house children orphaned by the 1918 Spanish Flu epidemic, the Jesse Lee Home for Children consisted of three main buildings (and a number of smaller ones) connected by covered arcades to ease movement during deep, dark, depressing arctic winters. As many as 120 children lived at the orphanage in the pre-War era, though less than 40 returned after the complex’s reversion to Methodist Church ownership following a camouflaged stint as Fort Raymond Army Base.
Image via: Friends Of The Jesse Lee Home/Facebook
The Great Alaskan Earthquake of March 27th, 1964 severely damaged the Jesse Lee Home for Children; there were no fatalities at the site but the Home’s largest building had to be demolished due to unrepairable damage. Since 1966 the property as a whole has been abandoned, and the use of asbestos insulation during its original construction has complicated efforts to either redevelop the site or raze it entirely.
Image via: Futurama Wiki
Are there still places for orphanages today…or even tomorrow? Regardless of the significant leaps society has made in the last few decades when it comes to children’s welfare, the age-old bugaboos of social stigma, prudishness, hypocrisy and familial irresponsibility still conspire to condemn our children to cold and oft-uncaring institutions like orphanages. If in a perfect world orphanages do not exist, then it would seem we’re not quite there yet.